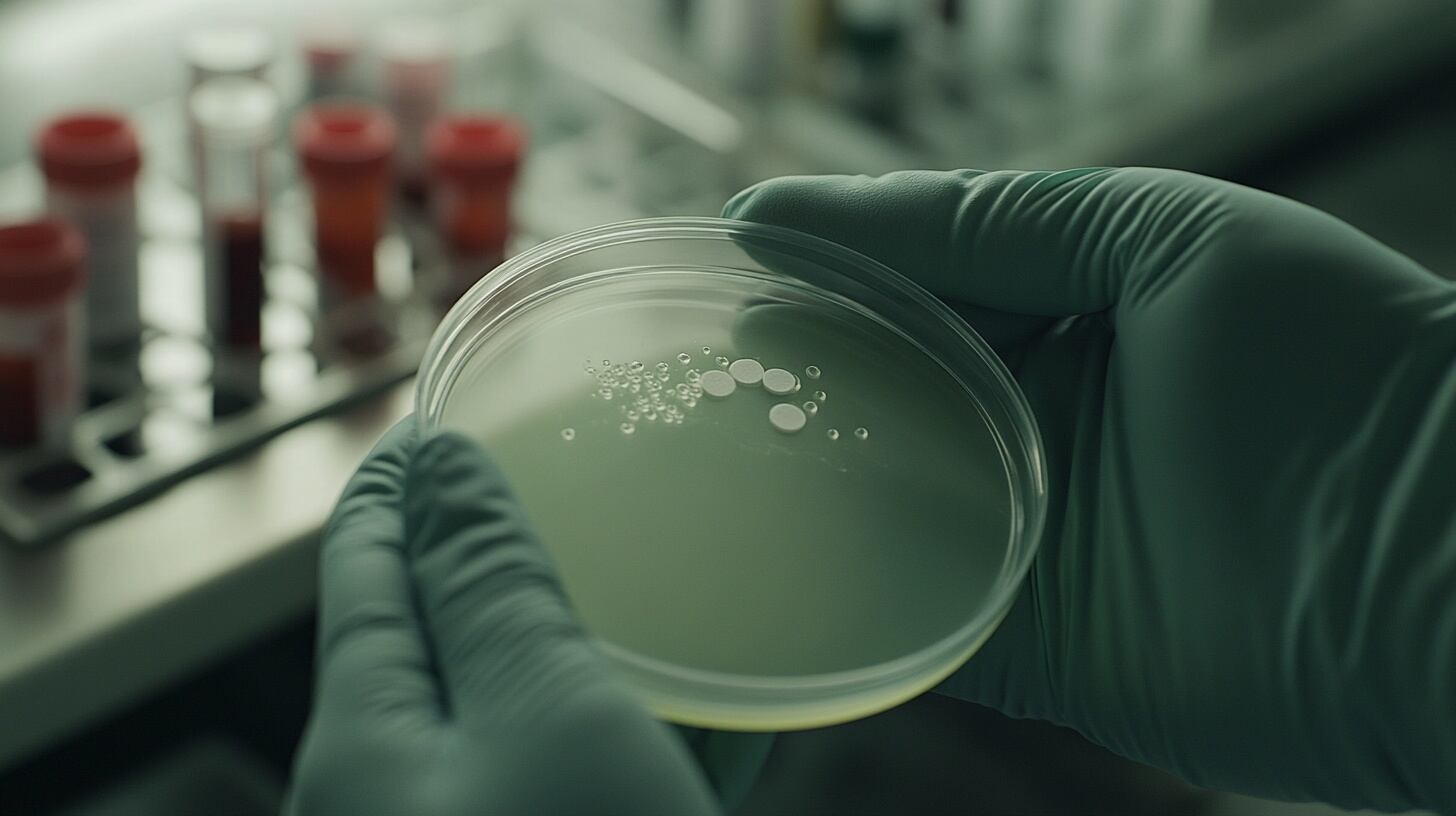

Napoleón Bonaparte fue uno de los líderes militares y políticos más influyentes de la historia de Europa. Su nombre se asocia con conquistas, reformas y uno de los episodios más trágicos: la invasión a Rusia en 1812.
Un ejército de medio millón de soldados franceses cayó ante el frío, el hambre y, según se creía hasta ahora, el tifus, la enfermedad infecciosa grave que puede ser transmitida principalmente por piojos.
Ahora, un equipo de científicos liderados por el argentino Nicolás Rascovan, que trabaja en el Instituto Pasteur de Francia, acaba de demostrar otra explicación sobre qué infecciones devastaron a los soldados de Napoléon.
El científico contó a Infobae cómo revelaron que el tifus no fue responsable de la mortandad masiva, como afirmaron fuentes históricas durante siglos. El hallazgo fue publicado en la revista Current Biology.

Colaboraron también investigadores de Lituania, la Universidad de Cambridge en el Reino Unido y del Centro Nacional para la Investigación Científica y la Agencia Nacional de Investigación de Francia.
El ADN extraído de restos hallados en Vilna, Lituania, permitió identificar otras enfermedades y replantear la narrativa sobre el desastre de la retirada napoleónica bajo la nieve rusa. Abrió un nuevo capítulo sobre la historia de las epidemias militares.
El misterio de las enfermedades
Durante décadas, la historia oficial sostuvo que el tifus, una enfermedad causada por la bacteria Rickettsia prowazekii, había terminado con muchos de los soldados durante la retirada de Moscú. Los médicos de la época y el hallazgo de piojos en restos reforzaron esa creencia.
Existía la posibilidad de que otras infecciones actuaran en simultáneo, pero la ausencia de pruebas genéticas mantenía la mirada fija en el tifus como responsable.
El equipo del doctor Rascovan intentó reexaminar la evidencia biológica en busca de causas diferentes. “Buscamos volver a analizar muestras de los soldados caídos de Napoleón y determinar si el tifus fue realmente la principal plaga en aquel invierno fatal”, contó el científico a Infobae.
Al contar con técnicas capaces de estudiar ADN antiguo, su equipo pudo explorar el verdadero impacto que tuvieron las enfermedades infecciosas.
Revelaciones de ADN histórico

El equipo analizó de manera exhaustiva los dientes de trece soldados, recuperados en una fosa común de Vilna, en la ruta de la retirada napoleónica.
Al procesar los dientes se protegió el ADN bacteriano de contaminaciones externas. De esta manera, se aseguró precisión en el estudio de los patógenos.
Cada muestra de ADN fue secuenciada con tecnología avanzada, que permite identificar fragmentos muy pequeños de material genético.
El método, mucho más sensible que la PCR usada en trabajos previos, permitió detectar microorganismos que hubieran pasado desapercibidos.

“No encontramos ningún rastro de tifus. En vez de la bacteria Rickettsia prowazekii que causa el tifus, identificamos Salmonella enterica, que provoca fiebre entérica o tifoidea, y Borrelia recurrentis, que es agente de la fiebre recurrente», puntualizó el científico.
Ambas enfermedades causan fiebre alta, debilidad extrema y pueden volverse letales en soldados exhaustos y malnutridos.
La principal sorpresa llegó con la cepa de Borrelia recurrentis. El análisis reveló que pertenece a un linaje presente en Gran Bretaña hace más de 2.000 años, lo que demuestra la persistencia de ciertos patógenos en Europa y su evolución a través del tiempo.
“Hay que considerar que lo que más golpeó a la Gran Armada de Napoleón fue el frío y el hambre tras invadir Rusia. Ahora hubo al menos cuatro infecciones que también impactaron en las personas al tener en cuenta un estudio anterior y el nuestro”, resaltó Rascovan en la entrevista con Infobae.
El hallazgo, que fue posible gracias al uso de la tecnología de ADN antiguo, desafía entonces la teoría más aceptada sobre la epidemia que devastó al ejército francés.
Los resultados también explican por qué trabajos previos indicaron la presencia de tifus: las técnicas más antiguas podían fallar por la degradación extrema del ADN. El nuevo enfoque permite obtener datos aún de fragmentos diminutos y muy viejos.
Tras los resultados, los investigadores sugirieron que se expanda el uso de la paleogenómica para estudiar otras tragedias históricas y reconstruir la evolución de los patógenos humanos.
Entre las limitaciones del estudio, señalaron el reducido número de muestras, debido a las dificultades para recuperar tejido genético de cuerpos expuestos a condiciones extremas durante siglos.
Reconocieron que los resultados corresponden a un grupo específico y no necesariamente a todos los soldados afectados.